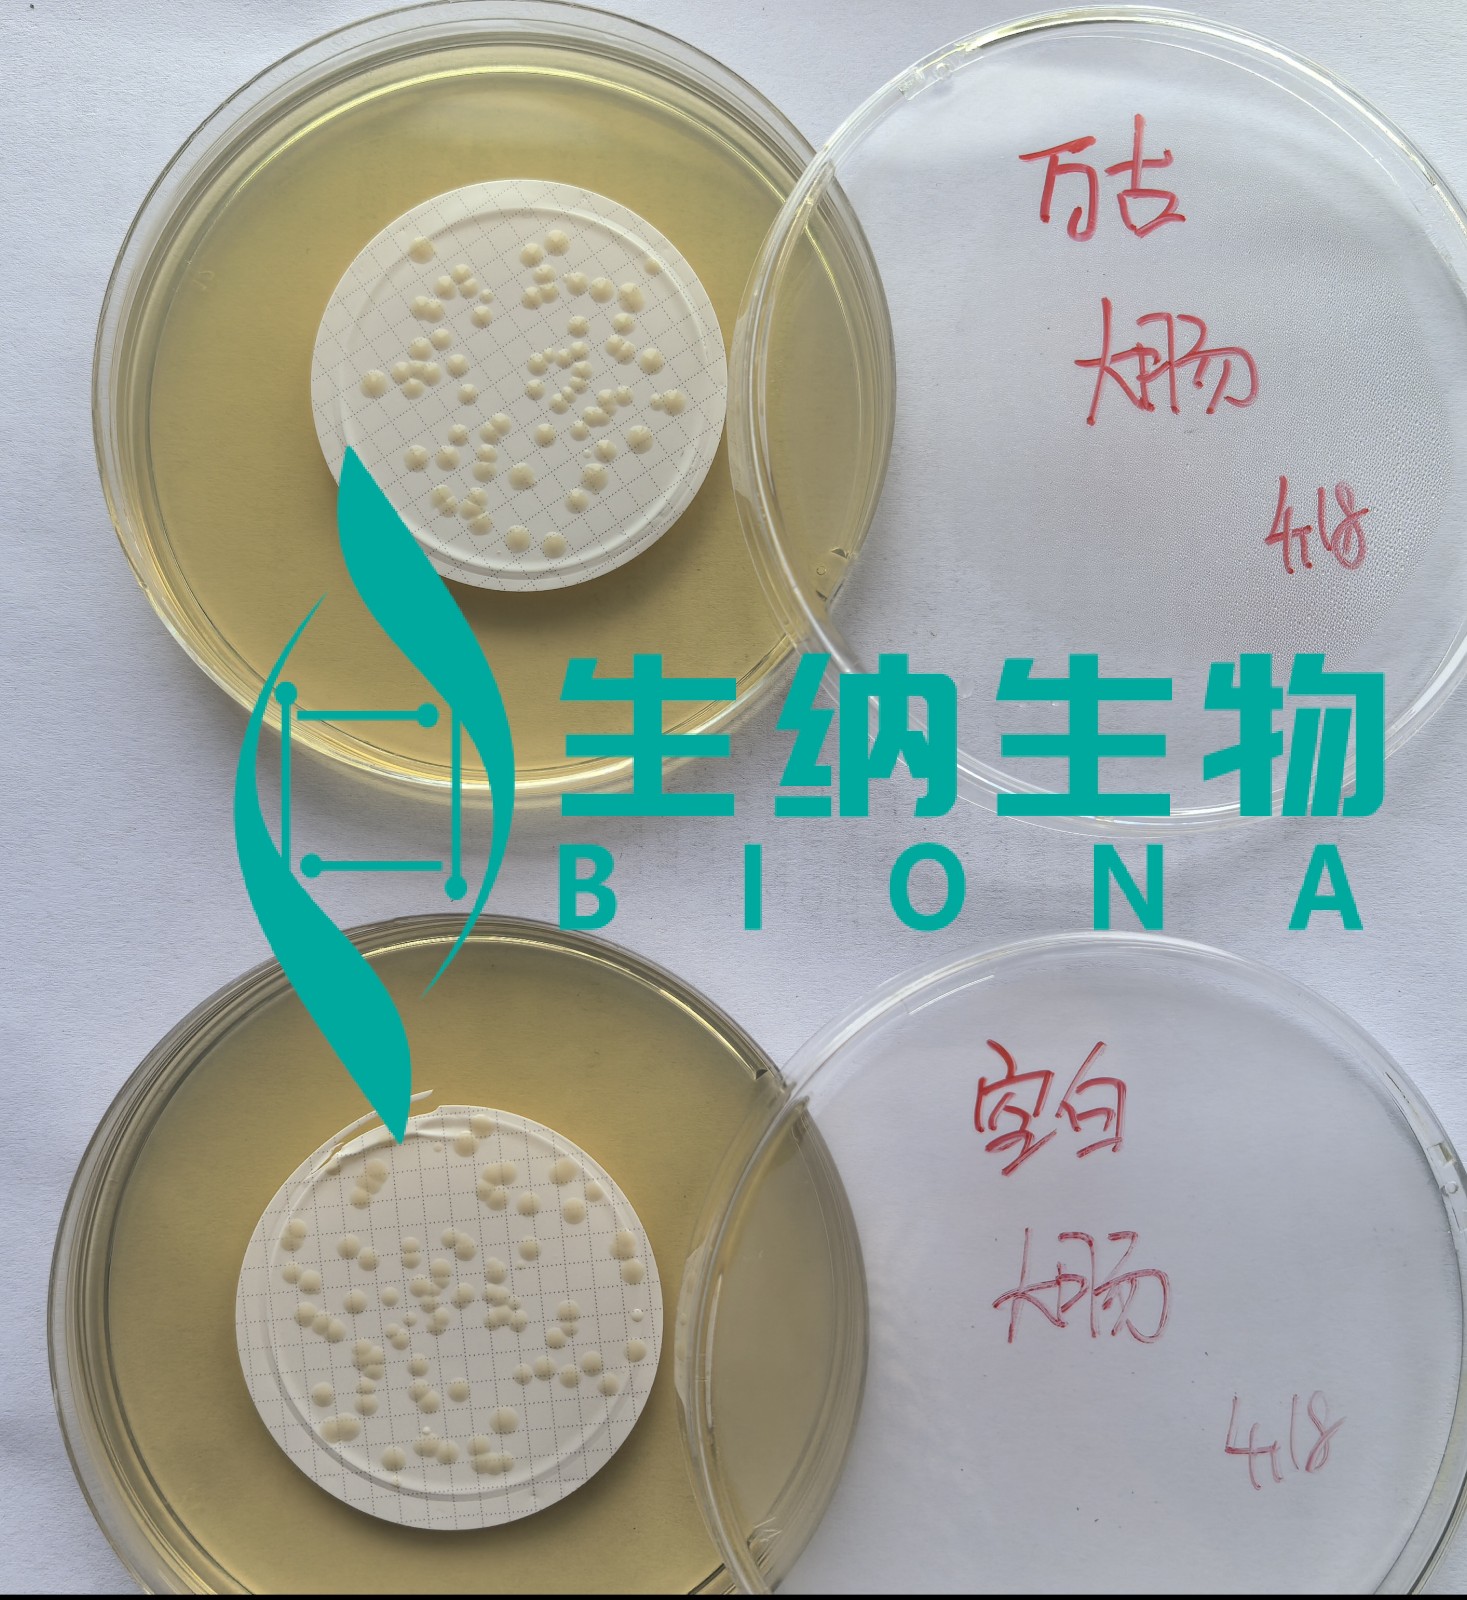

解决方案
万古霉素无菌及限度检查
发布时间 2025-10-24 浏览次数 252
底物:注射用盐酸万古霉素
中和剂:苏州生纳-万古霉素酶
冲洗量:500ml

底物:盐酸万古霉素原料药
中和剂:苏州生纳-万古霉素酶
回收率:金葡64%、大肠80%、枯草63%



底物:注射用盐酸万古霉素
中和剂:苏州生纳-万古霉素酶
冲洗量:500ml

底物:盐酸万古霉素原料药
中和剂:苏州生纳-万古霉素酶
回收率:金葡64%、大肠80%、枯草63%